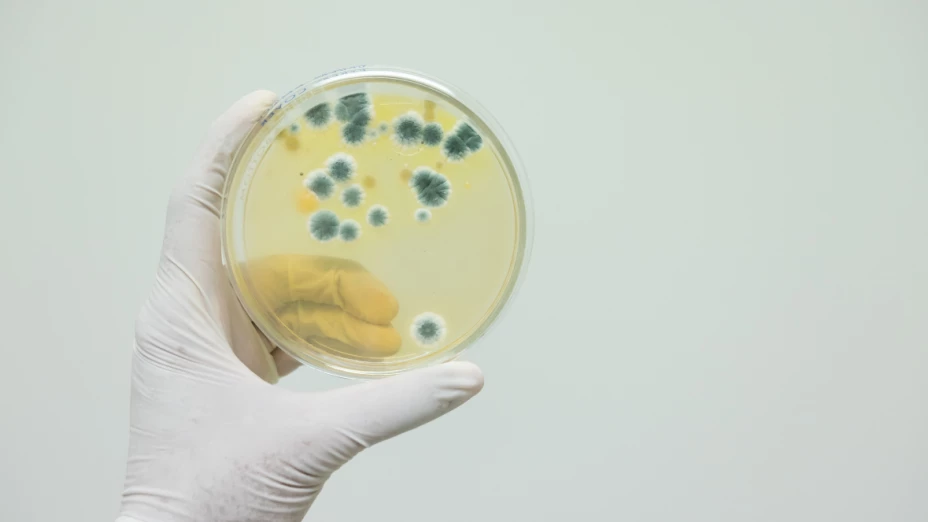
legionelosis

El Departamento de Salud de Nueva York confirmó un brote de legionelosis en el vecindario de Central Harlem que ha dejado seis personas fallecidas y al menos 112 casos confirmados. Además, siete pacientes permanecen hospitalizados a causa de esta enfermedad infecciosa provocada por la bacteria Legionella.
De acuerdo con las autoridades, se han identificado 12 torres de enfriamiento en diez edificios como los posibles focos de propagación. La bacteria se transmite principalmente por inhalación de aerosoles de agua contaminada, lo que explica su presencia en sistemas de refrigeración y aire acondicionado.
In Central Harlem, the source of the Legionnaires’ cluster is cooling towers. The bacteria is in the air, traveling across the neighborhood. That’s why we informed all residents, regardless of the building where they live or work. See my statement below. pic.twitter.com/sJtKNt1OV9
— Dr. Michelle Morse (@NYCHealthCommr) August 22, 2025
Una enfermedad silenciosa pero peligrosa
La legionelosis, también conocida como “enfermedad del legionario”, es provocada por la bacteria Legionella pneumophila, presente en el agua y en ambientes húmedos como torres de enfriamiento, sistemas de agua fría o caliente y humidificadores. Según la Organización Mundial de la Salud (OMS), el primer brote documentado ocurrió en 1976 en Filadelfia, relacionado con un mal mantenimiento de los sistemas hídricos.
La infección no se transmite de persona a persona, sino por inhalación de gotas de agua contaminada. Los síntomas pueden confundirse con los de una gripe común: fiebre, escalofríos, dolor muscular, cefalea y malestar general. En su forma pulmonar, puede derivar en neumonía severa, con un periodo de incubación de 2 a 10 días, manifestando tos, pérdida de apetito, letargo y diarrea.
Quizás te interese: Niño de 2 años muere ahogado durante su fiesta de cumpleaños en Ciudad Juárez
Prevención y recomendaciones
Hasta el momento, las autoridades sanitarias han descartado que el brote esté relacionado con el suministro de agua potable de los edificios, ya que el sistema de plomería es independiente al de enfriamiento. No obstante, se realizan inspecciones y limpieza de las torres de refrigeración de la zona afectada.
Actualmente no existe una vacuna contra la legionelosis. Las medidas de prevención se centran en el adecuado mantenimiento de las instalaciones que utilizan agua a temperaturas entre 20 y 50 °C, donde la bacteria puede proliferar. Se recomienda limpiar y desinfectar periódicamente las torres de enfriamiento, emplear biocidas como el cloro en instalaciones de hidromasaje y vaciar los sistemas semanalmente.
La situación en Harlem Central ha generado preocupación entre los residentes, aunque las autoridades insisten en que los controles sanitarios se han intensificado para contener el brote y evitar nuevas muertes.
📲 ¡Síguenos en nuestro canal de difusión de WhatsApp! —>Solo da clic aquí
Y para esta y más información, síguenos también en nuestras múltiples redes sociales: en Facebook nos encuentras como Azteca Chihuahua, vía Twitter @aztecachihuahua. Instagram como @tvaztecachihuahua y TikTok @tvaztecachihuahua o también visita más notas en nuestro sitio web www.aztecachihuahua.com
Quizás te interese: ¡Empeora la infestación! Este es el error más común al combatir cucarachas pequeñas en casa